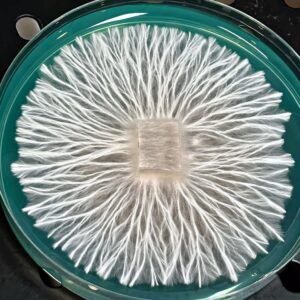

culture plate
Showing 417–448 of 842 resultsSorted by latest
-
See more products by: MICoFroots
-
See more products by: RockyMountainFamilyMycology
Albino Trinity Research Plate
Original price was: $20.00.$15.00Current price is: $15.00. -
See more products by: RockyMountainFamilyMycology
Albino Mystery 1219 Research Plate
Original price was: $20.00.$15.00Current price is: $15.00. -
See more products by: RockyMountainFamilyMycology
Syzygy Research Plate
Original price was: $20.00.$15.00Current price is: $15.00. -
See more products by: Humble Bruise
-
See more products by: Humble Bruise
-
See more products by: Controlled Chaos Genetics
SV-10 Premium Research Plate
Original price was: $15.00.$11.95Current price is: $11.95. -
See more products by: The Fungus Frequency
Brain Slugs Research Plate
$20.00 -
See more products by: Controlled Chaos Genetics
Shak x Ghost Premium Research Plate
Original price was: $15.00.$11.95Current price is: $11.95. -
See more products by: Humble Bruise
Toque Research Plate
$23.50 -
See more products by: Mushroom Empire
Mystery Box – Small
$50.00 -
See more products by: Mushroom Empire
Mystery Box – Large
$100.00 -
See more products by: Mushroom Empire
5 Pack Research Plates – Vendors Choice
Original price was: $70.00.$55.00Current price is: $55.00. -
See more products by: The Fungus Frequency
Pick 4 Research Plates for $60
Original price was: $70.00.$60.00Current price is: $60.00. -
See more products by: The Fungus Frequency
Pick 5 Research Plates for $70
Original price was: $80.00.$70.00Current price is: $70.00. -
See more products by: The Fungus Frequency
BlackHawk Research Plate
$20.00 -
See more products by: The Fungus Frequency
Haole Research Plate
$20.00 -
See more products by: MICoFroots
Ajax Research Plate
$20.00 -
See more products by: Controlled Chaos Genetics
Lightwave Premium Research Plate
Original price was: $15.00.$11.95Current price is: $11.95. -
See more products by: Controlled Chaos Genetics
Shak x Ghost Premium Research Plate
Original price was: $15.00.$11.95Current price is: $11.95. -
See more products by: Controlled Chaos Genetics
Rango APE Premium Research Plate
Original price was: $15.00.$11.95Current price is: $11.95. -
See more products by: Controlled Chaos Genetics
Stormtrooper Premium Research Plate
Original price was: $15.00.$11.95Current price is: $11.95. -
See more products by: Controlled Chaos Genetics
3-Way (Dirty South ISO) Premium Research Plate 60mm
Original price was: $15.00.$11.95Current price is: $11.95. -
See more products by: Controlled Chaos Genetics
Omni Bluewave Revert Premium Research Plate
Original price was: $15.00.$11.95Current price is: $11.95. -
See more products by: Controlled Chaos Genetics
Blue Ravioli Premium Research Plate
Original price was: $15.00.$11.95Current price is: $11.95. -
See more products by: Controlled Chaos Genetics
Toque F7 Premium Research Plate
Original price was: $15.00.$12.00Current price is: $12.00. -
See more products by: Controlled Chaos Genetics
Makilla Gorilla Premium Research Plate
Original price was: $15.00.$12.00Current price is: $12.00. -
See more products by: Controlled Chaos Genetics
Swamp Ghost Research Plate 60mm
Original price was: $15.00.$12.00Current price is: $12.00. -
See more products by: Controlled Chaos Genetics
P. Ochraceocentrata Premium Research Plate
Original price was: $18.00.$15.00Current price is: $15.00. -
See more products by: Controlled Chaos Genetics
Alacabenzi Premium Research Plate
Original price was: $15.00.$12.00Current price is: $12.00. -
See more products by: Controlled Chaos Genetics
Panaeolus Cyanescens Research Plate 60mm
Original price was: $18.00.$15.00Current price is: $15.00. -
See more products by: Controlled Chaos Genetics
Yoda’s Yeti Premium Research Plate
Original price was: $15.00.$12.00Current price is: $12.00.